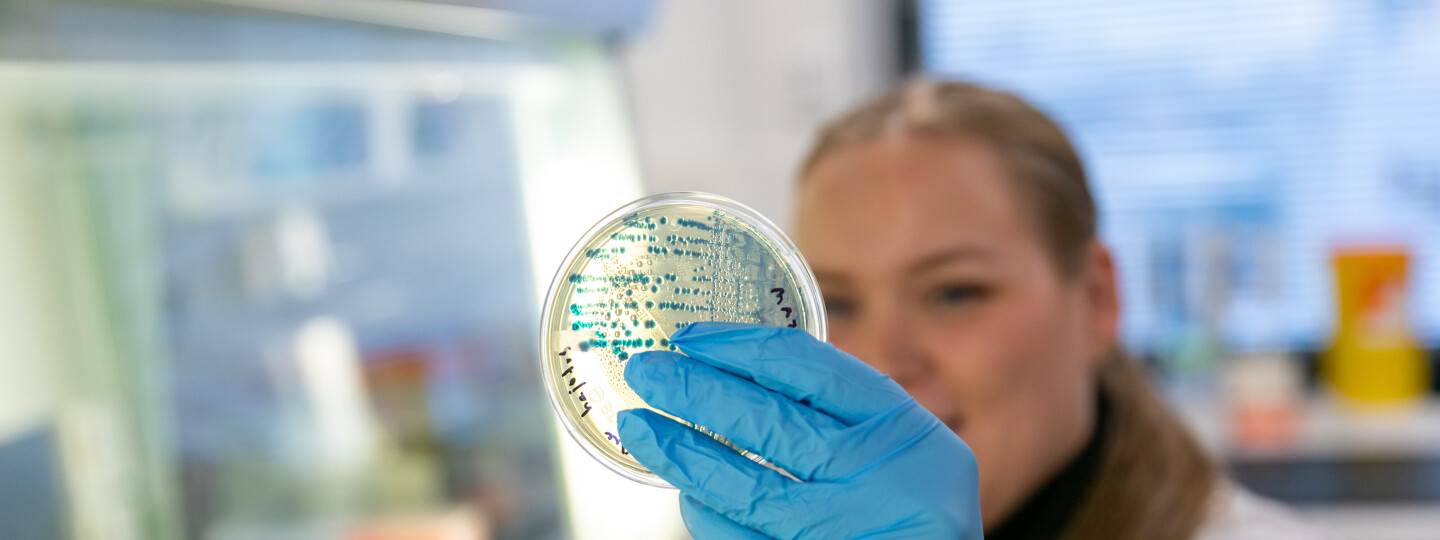

Turun yliopisto on kansainvälisesti kilpailukykyinen tiedeyliopisto, jonka toiminta perustuu korkeatasoiseen ja monialaiseen tutkimukseen. Haemme erityisesti tieteenalojen rajapinnoille sijoittuvia tieteellisiä läpimurtoja. Tutustu toimintaamme tutkimuksen saralla sekä tunnuslukuihin vuodelta 2023.